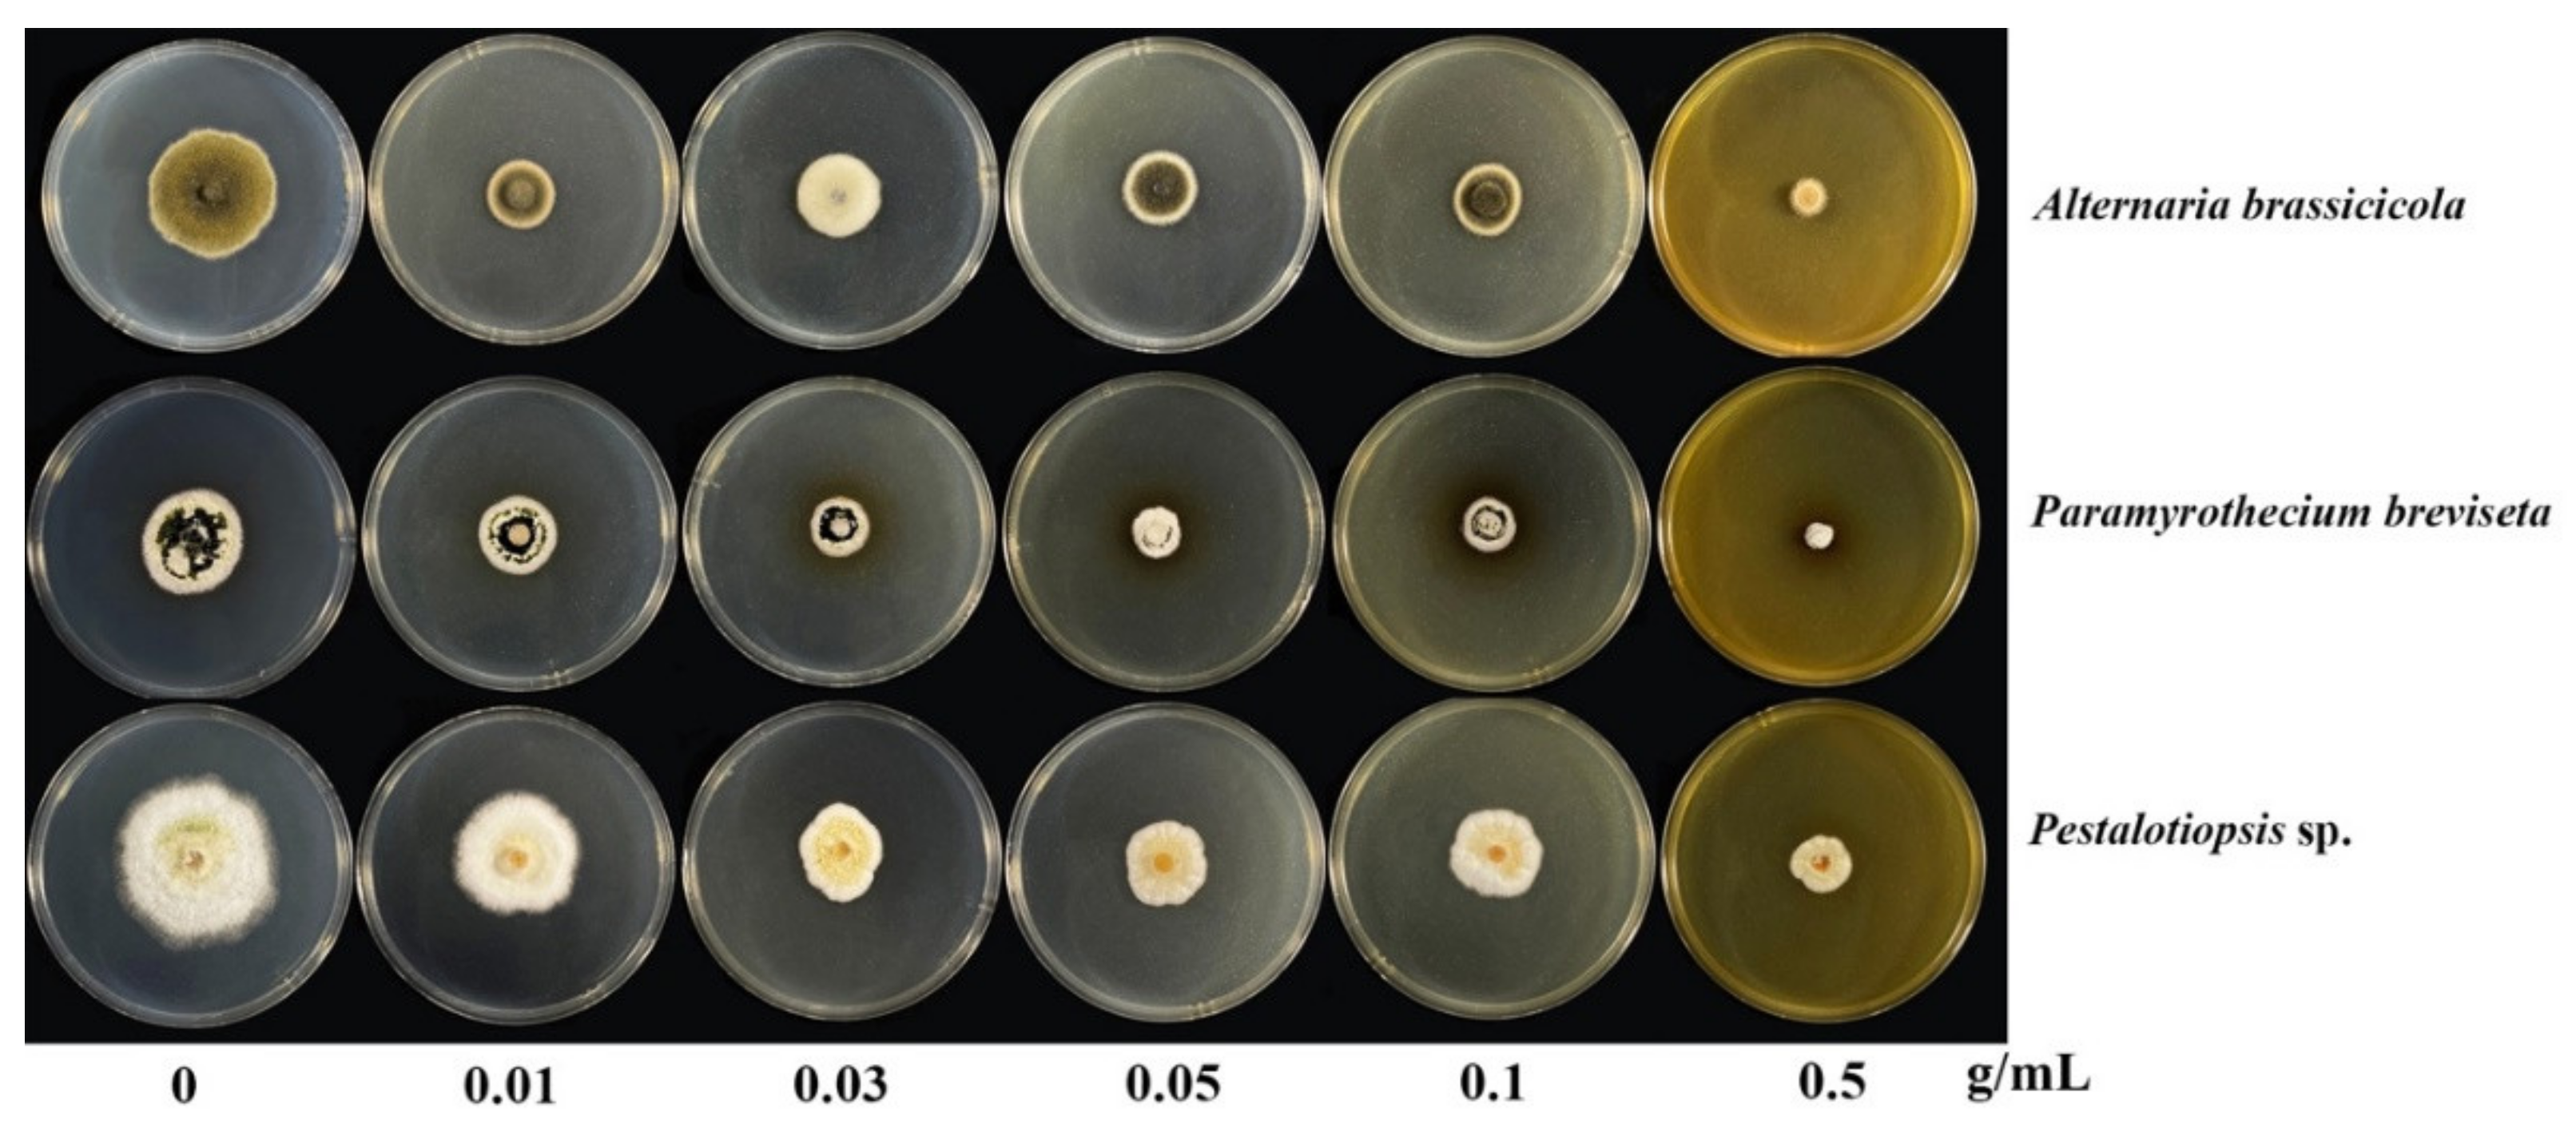
Plants 10 01422 g003 Plants 10 01422 g003

Recovery of Polyphenolic Fraction from Arabica Coffee Pulp and Its Antifungal Applications
Abstract
1. Introduction
2. Results and Discussion
2.1. The Phytochemical Profiles of Coffee Pulp Powder
2.2. Quantitative Polyphenol Analyses
2.3. Antifungal Activities
2.4. Chemometric Relations
3. Materials and Methods
3.1. Raw Material
3.2. Microorganisms
3.3. Proximate Analyses
3.4. Polyphenolic Fractions
3.5. Quantitative Polyphenol Analyses
3.5.1. Total Phenolic Content
3.5.2. Total Flavonoid Content
3.6. Antioxidant Activities
3.6.1. DPPH• Radical Scavenging Activity
3.6.2. Total Antioxidant Activity by ABTS•+ Radical Cation Decolourization Assay
3.7. Antifungal Activities
3.8. Quantitative Analysis of Phenolic and Flavonoid
3.9. Characterisation of the Methanolic Fraction on Quadrupole Time-of-Flight Mass Spectrometer (QTOF-MS)
3.10. Chemometric and Statistical Analyses
4. Conclusions
Supplementary Materials
Author Contributions
Funding
Institutional Review Board Statement
Informed Consent Statement
Data Availability Statement
Acknowledgments
Conflicts of Interest
References
- Lashermes, P.; Combes, M.-C.; Robert, J.; Trouslot, P.; D’Hont, A.; Anthony, F.; Charrier, A. Molecular characterisation and origin of the Coffea arabica L. genome. Mol. Gen. Genet. 1999, 261, 259–266. [Google Scholar] [CrossRef] [PubMed]
- Van der Vossen, H.; Bertrand, B.; Charrier, A. Next generation variety development for sustainable production of arabica coffee (Coffea arabica L.): A review. Euphytica 2015, 204, 243–256. [Google Scholar] [CrossRef]
- Food and Agriculture Organization (FAO). FAO Statistical Pocketbook Coffee. 2015; Food and Agriculture Organization (FAO): Rome, Italy, 2015; pp. 1–194. Available online: http://www.fao.org/3/i4985e/i4985e.pdf (accessed on 8 June 2021).
- Craparo, A.; Van Asten, P.J.; Läderach, P.; Jassogne, L.T.; Grab, S. Coffea arabica yields decline in Tanzania due to climate change: Global implications. Agric. For. Meteorol. 2015, 207, 1–10. [Google Scholar] [CrossRef]
- Davis, A.P.; Gole, T.W.; Baena, S.; Moat, J. The impact of climate change on indigenous arabica coffee (Coffea arabica): Predicting future trends and identifying priorities. PLoS ONE 2012, 7, e47981. [Google Scholar] [CrossRef]
- Esquivel, P.; Jimenez, V.M. Functional properties of coffee and coffee by-products. Food Res. Int. 2012, 46, 488–495. [Google Scholar] [CrossRef]
- Aristizábal-Marulanda, V.; Chacón-Perez, Y.; Cardona Alzate, C.A. Chapter 3—The biorefinery concept for the industrial valorization of coffee processing by-products. In Handbook of Coffee Processing By-Products; Galanakis, C.M., Ed.; Academic Press: Cambridge, MA, USA, 2017; pp. 63–92. [Google Scholar]
- Alves, R.C.; Rodrigues, F.; Nunes, M.A.; Vinha, A.F.; Oliveira, M.B.P. State of the art in coffee processing by-products. In Handbook of Coffee Processing by-Products; Elsevier: Amsterdam, The Netherlands, 2017; pp. 1–26. [Google Scholar]
- Blinová, L.; Sirotiak, M.; Bartošová, A.; Soldán, M. Review: Utilization of Waste from Coffee Production; Faculty of Materials Science and Technology in Trnava, Slovak University of Technology in Bratislava: Bratislava, Slovakia, 2017; Volume 25, pp. 91–101. [Google Scholar]
- Patay, É.B.; Sali, N.; Kőszegi, T.; Csepregi, R.; Balázs, V.L.; Németh, T.S.; Németh, T.; Papp, N. Antioxidant potential, tannin and polyphenol contents of seed and pericarp of three Coffea species. Asian Pac. J. 2016, 9, 366–371. [Google Scholar] [CrossRef]
- Ramirez-Martinez, J.R. Phenolic compounds in coffee pulp: Quantitative determination by HPLC. J. Sci. Food Agri. 1988, 43, 135–144. [Google Scholar] [CrossRef]
- Murthy, P.S.; Naidu, M.M. Recovery of phenolic antioxidants and functional compounds from coffee industry by-products. Food Bioproc. Tech. 2012, 5, 897–903. [Google Scholar] [CrossRef]
- Esquivel, P.; Viñas, M.; Steingass, C.B.; Gruschwitz, M.; Guevara, E.; Carle, R.; Schweiggert, R.M.; Jiménez, V.M. Coffee (Coffea arabica L.) by-products as a source of carotenoids and phenolic compounds—Evaluation of varieties with different peel color. Front. Sustain. Food Syst. 2020, 4, 187. [Google Scholar] [CrossRef]
- Ansari, M.A.; Anurag, A.; Fatima, Z.; Hameed, S. Natural phenolic compounds: A potential antifungal agent. Microbial pathogens and strategies for combating them. Sci. Technol. Educ. 2013, 1, 1189–1195. [Google Scholar]
- Konuk, H.B.; Ergüden, B. Phenolic–OH group is crucial for the antifungal activity of terpenoids via disruption of cell membrane integrity. Folia. Microbiol. 2020, 65, 775–783. [Google Scholar] [CrossRef]
- El-Khateeb, A.Y.; Elsherbiny, E.A.; Tadros, L.K.; Ali, S.M.; Hamed, H.B. Phytochemical analysis and antifungal activity of fruit leaves extracts on the mycelial growth of fungal plant pathogens. Plant Pathol. 2013, 4, 1–6. [Google Scholar]
- Ghasemi, M.; Aghajani, M.; Faraji, A.; Nejad, M.S. Relationship between incidence and severity of Alternaria blight disease on different species of Brassica in Gonbad region Iran. J. Plant Pathol. 2013, 49, 51–60. [Google Scholar]
- Pavicich, M.A.; Cárdenas, P.; Pose, G.N.; Pinto, V.F.; Patriarca, A. From field to process: How storage selects toxigenic Alternaria spp. causing mouldy core in red delicious apples. Int. J. Food Microbiol. 2020, 322, 108575. [Google Scholar] [CrossRef]
- Keith, L.M.; Velasquez, M.E.; Zee, F.T. Identification and characterization of Pestalotiopsis spp. causing scab disease of guava, Psidium guajava, in Hawaii. Plant Dis. 2006, 90, 16–23. [Google Scholar] [CrossRef]
- Ren, H.-Y.; Li, G.; Qi, X.-J.; Fang, L.; Wang, H.-R.; Wei, J.-G.; Zhong, S. Identification and characterization of Pestalotiopsis spp. causing twig blight disease of bayberry (Myrica rubra Sieb. & Zucc) in China. Eur. J. Plant Pathol. 2013, 137, 451–461. [Google Scholar]
- Hopkins, K.; McQuilken, M. Characteristics of Pestalotiopsis associated with hardy ornamental plants in the UK. Eur. J. Plant Pathol. 2000, 106, 77–85. [Google Scholar] [CrossRef]
- Chelong, I.-a.; Moye, J.J.; Adair, A.; Bonwanno, S. First report of efficacy study of bioextract to control Pestalotiopsis sp. Affecting para rubber leaf disease (Hevea brasiliensis Muell. Arg) under climate variability. Int. J. Adv. 2020, 11, 209–217. [Google Scholar]
- Soliman, M.S. Characterization of Paramyrothecium roridum (Basionym Myrothecium roridum) causing leaf spot of strawberry. J. Plant Prot. Res. 2020, 60, 141–149. [Google Scholar]
- Haudenshield, J.; Pawlowski, M.; Miranda, C.; Hartman, G. First report of Paramyrothecium roridum causing Myrothecium leaf spot on soybean in Africa. Plant Dis. 2018, 102, 2638. [Google Scholar] [CrossRef]
- Wu, W.; Zhu, M.; Liang, Y.; Bai, X.; Lu, Y.; Xi, J.; Huang, X.; Li, R.; Tan, S.; He, C.P. First report of Paramyrothecium breviseta causing leaf spot disease of Coffea canephora in China. Plant Dis. 2021, 11. [Google Scholar] [CrossRef]
- Setyobudi, R.; Wahono, S.; Adinurani, P.G.; Wahyudi, A.; Widodo, W.; Mel, M.; Nugroho, Y.; Prabowo, B.; Liwang, T. Characterisation of Arabica coffee pulp—Hay from Kintamani—Bali as prospective biogas feedstocks. MATEC Web Conf. 2018, 164, 01039. [Google Scholar] [CrossRef][Green Version]
- Frómeta, R.; Laencina Sánchez, J.; García, J. Evaluation of coffee pulp as substrate for polygalacturonase production in solid state fermentation. Emir. J. Food Agri. 2020, 32, 117–124. [Google Scholar] [CrossRef]
- Moreno, J.; Cozzano, S.; Pérez, A.; Arcia, P.; Curutchet, A. Coffee pulp waste as a functional ingredient: Effect on salty cookies quality. J. Food Nutr. Res. 2019, 7, 632–638. [Google Scholar] [CrossRef]
- Núñez, A.; Daniel, I.; Villagómez, M.; Martínez, P.; Sánchez, C.; Pulido, S.; Rojas-Ronquillo, R. The use of coffee pulp as a potential alternative supplement in ruminant diets. Agric. Sci. Technol. 2015, 5, 214–217. [Google Scholar]
- Rios, T.; Sánchez-Torres, M.T.; Ortega, M.; Soto-hernandez, M.; Díaz-Cruz, A.; Bautista, J.; Cuéllar, C.; Vaquera Huerta, H. Changes in composition, antioxidant content, and antioxidant capacity of coffee pulp during the ensiling process. Rev. Bras. Zootec. 2014, 43, 492–498. [Google Scholar] [CrossRef]
- Ameca, G.; Ortega, M.; Zetina-Córdoba, P.; Díaz-Cruz, A.; Soto-hernandez, M.; Haro, J. Chemical composition and antioxidant capacity of coffee pulp. Ciênc. Agrotec. 2018, 42, 307–313. [Google Scholar] [CrossRef]
- Brummell, D.A. Cell wall disassembly in ripening fruit. Funct. Plant Biol. 2006, 33, 103–119. [Google Scholar] [CrossRef]
- Mota, D.; Santos, J.; Faria, D.; Lima, Á.; Krause, L.; Soares, C.; Ferreira-Dias, S. Synthesis of dietetic structured lipids from spent coffee grounds crude oil catalyzed by commercial immobilized lipases and immobilized Rhizopus oryzae lipase on biochar and hybrid support. Processes 2020, 8, 1542. [Google Scholar] [CrossRef]
- Japir, A.A.-W.M.M.; Salimon, J.; Derawi, D.; Yahaya, B.; Bahadi, M.; Al-Shuja’a, S.; Yusop, R. A highly efficient separation and physicochemical characteristics of saturated fatty acids from crude palm oil fatty acids mixture using methanol crystallisation method. OCL 2018, 25, A203. [Google Scholar] [CrossRef]
- Hurtado, J.G.F.; Abarca, J.M. Quantification of K, Ca, Mg y P minerals in coffee (Coffea arabica L. var. Typica) pulp and parchment. Rev. Venez. Cienc. Tecnol. Aliment. 2010, 1, 221–230. [Google Scholar]
- Khan, N.; Ruqia, B.; Hussain, J.; Jamila, N.; Ur, N.; Rahman; Hussain, S.T. Nutritional assessment and proximate analysis of selected vegetables from Parachinar Kurram agency. Am. J. Res. Comm. 2013, 1, 184–198. [Google Scholar]
- Geremu, M.; Tola, Y.; Sualeh, A. Extraction and determination of total polyphenols and antioxidant capacity of red coffee (Coffea arabica L.) pulp of wet processing plants. Chem. Biol. Technol. Agric. 2016, 3, 1–6. [Google Scholar] [CrossRef]
- Alothman, M.; Bhat, R.; Karim, A.A. Antioxidant capacity and phenolic content of selected tropical fruits from Malaysia, extracted with different solvents. Food Chem. 2009, 115, 785–788. [Google Scholar] [CrossRef]
- Kim, D.-O.; Lee, C.Y. Extraction and isolation of polyphenolics. Crit. Rev. Biotechnol. 2002, 6, 1–22. [Google Scholar] [CrossRef]
- Vladimir-Knežević, S.; Blažeković, B.; Bival Štefan, M.; Babac, M. Plant polyphenols as antioxidants influencing the human health. In Phytochemicals as Nutraceuticals—Global Approaches to Their Role in Nutrition and Health; IntechOpen: London, UK, 2011; pp. 155–180. [Google Scholar]
- Delgado, S.R.; Arbelaez, A.F.A.; Rojano, B. Antioxidant capacity, bioactive compounds in coffee pulp and implementation in the production of infusions. Acta Sci. Pol. Technol. Aliment. 2019, 18, 235–248. [Google Scholar]
- Rodríguez-Carpena, J.G.; Morcuende, D.; Andrade, M.J.; Kylli, P.; Estévez, M. Avocado (Persea americana Mill.) phenolics, in vitro antioxidant and antimicrobial activities, and inhibition of lipid and protein oxidation in porcine patties. J. Agric. Food Chem. 2011, 59, 5625–5635. [Google Scholar] [CrossRef]
- Naczk, M.; Shahidi, F. Phenolics in cereals, fruits and vegetables: Occurrence, extraction and analysis. J. Pharm. Biomed. Anal. 2006, 41, 1523–1542. [Google Scholar] [CrossRef]
- Zhao, H.; Dong, J.; Lu, J.; Chen, J.; Li, Y.; Shan, L.; Lin, Y.; Fan, W.; Gu, G. Effects of extraction solvent mixtures on antioxidant activity evaluation and their extraction capacity and selectivity for free phenolic compounds in barley (Hordeum vulgare L.). J. Agric. Food Chem. 2006, 54, 7277–7286. [Google Scholar] [CrossRef]
- Xu, B.J.; Chang, S.K. A comparative study on phenolic profiles and antioxidant activities of legumes as affected by extraction solvents. J. Food Sci. 2007, 72, 159–166. [Google Scholar] [CrossRef]
- Scalbert, A.; Johnson, I.T.; Saltmarsh, M. Polyphenols: Antioxidants and beyond. Am. J. Clin. Nutr. 2005, 81, 215–217. [Google Scholar] [CrossRef]
- Heeger, A.; Kosińska-Cagnazzo, A.; Cantergiani, E.; Andlauer, W. Bioactives of coffee cherry pulp and its utilisation for production of Cascara beverage. Food Chem. 2017, 221, 969–975. [Google Scholar] [CrossRef]
- Martinez-Saez, N.; Ullate, M.; Martin-Cabrejas, M.A.; Martorell, P.; Genovés, S.; Ramon, D.; del Castillo, M.D. A novel antioxidant beverage for body weight control based on coffee silverskin. Food Chem. 2014, 150, 227–234. [Google Scholar] [CrossRef]
- Arjin, C.; Hongsibsong, S.; Pringproa, K.; Seel-audom, M.; Ruksiriwanich, W.; Sutan, K.; Sommano, S.R.; Sringarm, K. Effect of ethanolic Caesalpinia sappan fraction on in vitro antiviral activity against porcine reproductive and respiratory syndrome virus. Vet. Sci. 2021, 8, 106. [Google Scholar] [CrossRef]
- Sommano, S.R.; Suppakittpaisarn, P.; Sringarm, K.; Junmahasathien, T.; Ruksiriwanich, W. Recovery of crocins from floral tissue of Gardenia jasminoides Ellis. Front. Nutri. 2020, 7, 106. [Google Scholar] [CrossRef]
- Gupta, P.; Chandra, R.; Dubey, P. Bio-efficacy of plants extract against Alternaria brassicicola causing Alternaria leaf spot of cabbage. J. Pharmacogn. Phytochem. 2019, 8, 2332–2334. [Google Scholar]
- Chen, T.; Lu, J.; Kang, B.; Lin, M.; Ding, L.; Zhang, L.; Chen, G.; Chen, S.; Lin, H. Antifungal activity and action mechanism of ginger oleoresin against Pestalotiopsis microspora isolated from Chinese olive fruits. Front. Microbiol. 2018, 9, 2583. [Google Scholar] [CrossRef]
- Khantham, C.; Yooin, W.; Sringarm, K.; Sommano, S.R.; Jiranusornkul, S.; Carmona, F.D.; Nimlamool, W.; Jantrawut, P.; Rachtanapun, P.; Ruksiriwanich, W. Effects on steroid 5-alpha reductase gene expression of Thai rice bran extracts and molecular dynamics study on SRD5A2. Biology 2021, 10, 319. [Google Scholar] [CrossRef]
- Suksathan, R.; Rachkeeree, A.; Puangpradab, R.; Kantadoung, K.; Sommano, S.R. Phytochemical and nutritional compositions and antioxidants properties of wild edible flowers as sources of new tea formulations. NFS J. 2021, 24, 15–25. [Google Scholar] [CrossRef]
- Wongkaew, M.; Tinpovong, B.; Sringarm, K.; Leksawasdi, N.; Jantanasakulwong, K.; Rachtanapun, P.; Hanmoungjai, P.; Sommano, S.R. Crude pectic oligosaccharide recovery from Thai chok anan mango peel using pectinolytic enzyme hydrolysis. Foods 2021, 10, 627. [Google Scholar] [CrossRef]
- Riaz, U.; Kharal, M.A.; Murtaza, G.; uz Zaman, Q.; Javaid, S.; Malik, H.A.; Aziz, H.; Abbas, Z. Prospective roles and mechanisms of caffeic acid in counter plant stress: A mini review. Pak. J. Agric. Sci. 2019, 32, 8. [Google Scholar] [CrossRef]
- Sánchez-Maldonado, A.F.; Schieber, A.; Gänzle, M.G. Antifungal activity of secondary plant metabolites from potatoes (Solanum tuberosum L.): Glycoalkaloids and phenolic acids show synergistic effects. J. Appl. Microbiol. 2016, 120, 955–965. [Google Scholar] [CrossRef]
- Ravn, H.; Andary, C.; Kovács, G.; Mølgaard, P. Caffeic acid esters as in vitro inhibitors of plant pathogenic bacteria and fungi. Biochem. Syst. Ecol. 1989, 17, 175–184. [Google Scholar] [CrossRef]
- Matsumoto, Y.; Kaihatsu, K.; Nishino, K.; Ogawa, M.; Kato, N.; Yamaguchi, A. Antibacterial and antifungal activities of new acylated derivatives of epigallocatechin gallate. Front. Microbiol. 2012, 3, 53. [Google Scholar] [CrossRef]
- Jiang, X.; Feng, K.; Yang, X. In vitro Antifungal Activity and Mechanism of action of tea polyphenols and tea saponin against Rhizopus stolonifer. Adv. Microb. Physiol. 2015, 25, 269–276. [Google Scholar] [CrossRef]
- Duguma, H.; Aga, M. Review on coffee (Coffea arabica L.) wet processing more focus in Ethiopia. Acta Sci. Agric. 2019, 3, 11–15. [Google Scholar] [CrossRef]
- Wongkaew, M.; Kittiwachana, S.; Phuangsaijai, N.; Tinpovong, B.; Tiyayon, C.; Pusadee, T.; Chuttong, B.; Sringarm, K.; Bhat, F.M.; Sommano, S.R. Fruit characteristics, peel nutritional compositions, and their relationships with mango peel pectin quality. Plants 2021, 10, 1148. [Google Scholar] [CrossRef]
- Senanayake, I.; Rathnayake, A.; Marasinghe, D.; Calabon, M.; Gentekaki, E.; Lee, H. Morphological approaches in studying fungi: Collection, examination, isolation, sporulation and preservation. Mycosphere 2020, 11, 2678–2754. [Google Scholar] [CrossRef]
- Dethoup, T.; Songkumarn, P.; Rueangrit, S.; Suesa-ard, S.; Kaewkrajay, C. Fungicidal activity of Thai medicinal plant extracts against Alternaria brassicicola causing black spot of Chinese kale. Eur. J. Plant. Pathol. 2018, 152, 157–167. [Google Scholar] [CrossRef]
- Wisetkomolmat, J.; Inta, A.; Krongchai, C.; Kittiwachana, S.; Jantanasakulwong, K.; Rachtanapun, P.; Rose Sommano, S. Ethnochemometric of plants traditionally utilised as local detergents in the forest dependent culture. Saudi Res. J. Biol. Sci. 2021, 28, 2858–2866. [Google Scholar] [CrossRef]
- Sunanta, P.; Chung, H.H.; Kunasakdakul, K.; Ruksiriwanich, W.; Jantrawut, P.; Hongsibsong, S.; Sommano, S.R. Genomic relationship and physiochemical properties among raw materials used for Thai black garlic processing. Food Sci. Nutr. 2020, 8, 4534–4545. [Google Scholar] [CrossRef] [PubMed]
- Adedapo, A.A.; Jimoh, F.O.; Afolayan, A.J.; Masika, P.J. Antioxidant activities and phenolic contents of the methanol extracts of the stems of Acokanthera oppositifolia and Adenia gummifera. Altern. Med. 2008, 8, 54. [Google Scholar] [CrossRef] [PubMed]
- Lux, P.; Freiling, M.; Stuetz, W.; Tucher, S.; Carle, R.; Steingass, C.; Frank, J. (Poly)phenols, carotenoids, and tocochromanols in corn (Zea mays L.) kernels as affected by phosphate fertilization and sowing time. J. Agric. Food Chem. 2020, 68, 612–622. [Google Scholar] [CrossRef] [PubMed]
- Wang, H.; Helliwell, K.; You, X. Isocratic elution system for the determination of catechins, caffeine and gallic acid in green tea using HPLC. Food Chem. 2000, 68, 115–121. [Google Scholar] [CrossRef]
- Bosmali, I.; Lagiotis, G.; Stavridou, E.; Haider, N.; Osathanunkul, M.; Pasentsis, K.; Madesis, P. Novel authentication approach for coffee beans and the brewed beverage using a nuclear-based species-specific marker coupled with high resolution melting analysis. Food Sci. Technol. 2021, 137, 110336. [Google Scholar]

| Coffee Pulp Powder | ||
|---|---|---|
| Compositions | Before extraction (BCF) | After extraction (ACF) |
| Moisture (%w/w) | 5.98 ± 0.538 | 6.12 ± 0.02 |
| Carbohydrate (%w/w) | 62.78 ± 0.756 | 61.93 ± 1.45 |
| Crude fibre (%w/w) | 15.69 ± 0.66 | 18.27 ± 1.03 |
| Crude protein (%w/w) | 11.13 ± 0.009 | 12.09 ± 0.25 * |
| Crude fat (%w/w) | 4.10 ± 0.265 | 1.23 ± 0.19 * |
| Ash (%w/w) | 0.32 ± 0.009 | 0.36 ± 0.11 |
| %Yield methanol extract | 6.64 ± 1.911 | - |
| %Yield dichloromethane extract | 2.27 ± 0.287 | - |
| Crude extracts | ||
| Polyphenols (μg/g dried sample) | Methanol | Dichloromethane |
| Total flavonoid content | 1.03 ± 0.00 | n/d |
| Total phenolic content | 0.56 ± 0.00 | n/d |
| Antioxidant activities (%) | ||
| ABTS | 93.13 ± 0.64 | 56.09 ± 0.52 |
| DPPH | 99.44 ± 0.40 | 65.22 ± 5.32 |
| Compositions | Methanol | |
|---|---|---|
| Flavonoid compounds (mg/g extract) | Epigallocatechin gallate | 31.76 ± 0.34 |
| Naringin | 9.63 ± 0.00 | |
| Epicatechin | 8.66 ± 0.01 | |
| gallate | ||
| Catechin | 2.41 ± 0.15 | |
| Gallocatechin | 0.12 ± 0.00 | |
| gallate | ||
| Quercetin | 5.42 ± 0.00 | |
| Non-flavonoid compound (mg/g extract) | Caffeic acid | 68.05 ± 0.45 |
| Caffeine | 21.59 ± 0.00 | |
| P-coumaric | 11.04 ± 0.02 | |
| Rosmarinic acid | 6.41 ± 0.00 | |
| O-coumaric | 6.24 ± 0.01 | |
| Gallic acid | 2.41 ± 0.15 | |
| Polyphenol Groups | Relation Time | CAS No. | m/z Values | Formula | Compounds | Matching Score | |||
|---|---|---|---|---|---|---|---|---|---|
| (M + H)+ | (M + NH4)+ | (M + Na)+ | (M + CH3COO)− | ||||||
| Flavonoid | - | 989-51-5 | - | - | - | - | C22 H18 O11 | Epigallocatechin gallate | - |
| - | 10236-47-2 | - | - | - | - | C15 H12 O5 | Naringenin | - | |
| - | 1257-08-5 | - | - | - | - | C22 H18 O10 | Epicatechin gallate | - | |
| - | 154-23-4 | - | - | - | - | C15 H14 O6 | Catechin | - | |
| - | 4233-96-9 | - | - | - | - | C22 H18 O11 | Gallocatechin gallate | - | |
| 1.203 | 117-39-5 | - | - | - | 361.0544 | C15 H10 O7 | Quercetin | 85.56 | |
| Non-flavonoid | - | 331-393-5 | - | - | - | - | C9 H8 O4 | Caffeic acid | - |
| - | 501-98-4 | - | - | - | - | C9 H8 O3 | p-coumaric | - | |
| - | 20283-92-5 | - | - | - | - | C18 H16 O8 | Rosmarinic acid | - | |
| - | 614-60-8 | - | - | - | - | C9 H8 O3 | O-coumaric | - | |
| 1.222 | 149-91-7 | 171.0288 | - | 193.0117 | - | C7 H6 O5 | Gallic acid | 95.51 | |
| 1.288 | 58-08-2 | 195.0877 | 212.1126 | 217.0747 | - | C8 H10 N4 O2 | Caffeine (alkaloid) | 98.03 | |
| Alternaria brassicicola | Pestalotiopsis sp. | Paramyrothecium breviseta | |||||||||||||
|---|---|---|---|---|---|---|---|---|---|---|---|---|---|---|---|
| Extract Concentration (g/mL) | 0.01 | 0.03 | 0.05 | 0.10 | 0.50 | 0.01 | 0.03 | 0.05 | 0.10 | 0.50 | 0.01 | 0.03 | 0.05 | 0.10 | 0.50 |
| %Inhibition | 41.02 ± 4.44 a | 48.71 ± 1.48 ab | 52.14 ± 3.08 b | 45.30 ± 2.26 ab | 70.94 ± 0.85 c | 29.12 ± 8.09 a | 35.44 ± 5.74 a | 31.23 ± 8.63 a | 32.63 ± 9.95 a | 62.10 ± 5.57 b | 37.50 ± 7.22 a | 42.71 ± 2.75 a | 41.66 ± 5.80 a | 47.92 ± 5.21 a | 78.12 ± 3.12 b |
| IC50 | 0.09 | 0.31 | 0.14 | ||||||||||||
| Spore counts | 8.90 ±1.5 bc × 10−4 | 1.31 ± 0.01 c × 10−5 | 4.9 ± 0.004 ac × 10−4 | 1.1 ± 0.001 a × 10−4 | 0 ± 0.0 a | n/a | n/a | n/a | n/a | n/a | 9.85 ± 0.001 × 10−5 | 5.85 ± 0.004 b × 10−5 | 5.2 ± 0.0002 c × 10−5 | 6.70 ± 0.001 a × 10−4 | 0 ± 0.0 a |
| Spore morphology | |||||||||||||||
| Length | 15.05 ± 0.89 b | 14.55 ± 1.36 b | 12.85 ± 0.84 b | 12.85 ± 1.00 b | 0 ± 0.0 a | n/a | n/a | n/a | n/a | n/a | 6.65 ± 0.10 bc | 6.76 ± 0.12 c | 6.37 ± 0.01 b | 6.65 ± 0.10 bc | 0 ± 0.0 a |
| Width | 8.56 ± 0.17 c | 8.51 ± 0.21 c | 8.38 ± 0.19 c | 7.12 ± 0.33 b | 0 ± 0.0 a | n/a | n/a | n/a | n/a | n/a | 1.95 ± 0.05 b | 2.03 ± 0.05 b | 2.22 ± 0.41 c | 1.95 ± 0.45 b | 0 ± 0.0 a |
| Cell wall thickness | 1.03 ± 0.04 c | 0.95 ± 0.04 c | 0.08 ± 0.04 c | 0.69 ± 0.03 b | 0 ± 0.0 a | n/a | n/a | n/a | n/a | n/a | n/a | n/a | n/a | n/a | n/a |
| Mycelial morphology | |||||||||||||||
| Width | 4.39 ± 0.11 c | 3.99 ± 0.17 bc | 3.39 ± 0.15 a | 3.67 ± 0.14 ab | 3.88 ± 0.15 b | 2.63 ± 0.11 ab | 3.80 ± 0.15 c | 3.01 ± 0.15 b | 2.87 ± 0.14 b | 2.40 ± 0.12 a | 2.45 ± 0.77 a | 3.09 ± 0.08 c | 3.04 ± 0.01 c | 2.7 ± 0.08 b | 3.040 ± 0.1 c |
| Cell wall thickness | 0.54 ± 0.02 d | 0.53 ± 0.02 d | 0.47 ± 0.03 c | 0.30 ± 0.02 b | 0.184 ± 0.01 a | n/a | n/a | n/a | n/a | n/a | n/a | n/a | n/a | n/a | n/a |
Publisher’s Note: MDPI stays neutral with regard to jurisdictional claims in published maps and institutional affiliations. |
© 2021 by the authors. Licensee MDPI, Basel, Switzerland. This article is an open access article distributed under the terms and conditions of the Creative Commons Attribution (CC BY) license (https://creativecommons.org/licenses/by/4.0/).
Share and Cite
Sangta, J.; Wongkaew, M.; Tangpao, T.; Withee, P.; Haituk, S.; Arjin, C.; Sringarm, K.; Hongsibsong, S.; Sutan, K.; Pusadee, T.; et al. Recovery of Polyphenolic Fraction from Arabica Coffee Pulp and Its Antifungal Applications. Plants 2021, 10, 1422. https://doi.org/10.3390/plants10071422
Sangta J, Wongkaew M, Tangpao T, Withee P, Haituk S, Arjin C, Sringarm K, Hongsibsong S, Sutan K, Pusadee T, et al. Recovery of Polyphenolic Fraction from Arabica Coffee Pulp and Its Antifungal Applications. Plants. 2021; 10(7):1422. https://doi.org/10.3390/plants10071422
Chicago/Turabian StyleSangta, Jiraporn, Malaiporn Wongkaew, Tibet Tangpao, Patchareeya Withee, Sukanya Haituk, Chaiwat Arjin, Korawan Sringarm, Surat Hongsibsong, Kunrunya Sutan, Tonapha Pusadee, and et al. 2021. "Recovery of Polyphenolic Fraction from Arabica Coffee Pulp and Its Antifungal Applications" Plants 10, no. 7: 1422. https://doi.org/10.3390/plants10071422
APA StyleSangta, J., Wongkaew, M., Tangpao, T., Withee, P., Haituk, S., Arjin, C., Sringarm, K., Hongsibsong, S., Sutan, K., Pusadee, T., Sommano, S. R., & Cheewangkoon, R. (2021). Recovery of Polyphenolic Fraction from Arabica Coffee Pulp and Its Antifungal Applications. Plants, 10(7), 1422. https://doi.org/10.3390/plants10071422










